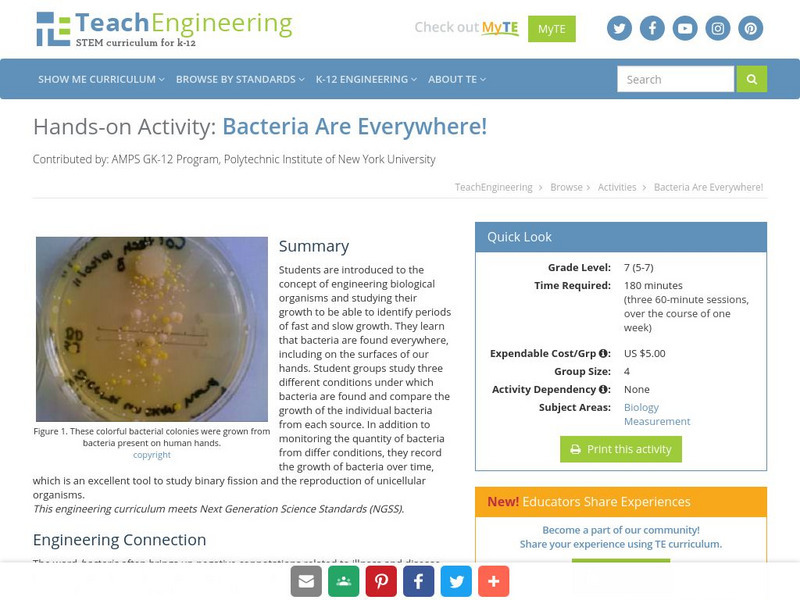

Hi, what do you want to do?
Curated OER
What is Biology?
In this biology worksheet, students review the characteristics of life and the scientific method. This worksheet has 19 fill in the blank, 6 matching, and 2 short answer questions.
Curated OER
What is Life?
Students investigate the characteristics of living things. In this life science lesson, students examine several living and non-living specimens. Students determine which things are living and non-living.
Curated OER
Threatened, Endangered & Extinct Lesson Plan
Students examine the basic needs of living organisms. For this science lesson, students study ecosystems and discover that organisms have basic needs that must be met.
Curated OER
English Vocabulary Skills: AWL Sublist 6 - Exercise 4b
In this online interactive English vocabulary skills worksheet, students answer 10 matching questions which require them to fill in the blanks in 10 sentences. Students may submit their answers to be scored.
Curated OER
The Shape of Things
Students explore dome shape construction. In this dome shape construction lesson, students explore the history, strength, and endurance of the dome shape design.
Curated OER
What Are We?
Young scholars describe different types of water pollutants. They complete experiments in which they observe the affects of water pollution on algae. They also brainstorm and list three causes of each water pollutant.
Curated OER
This Old Tubeworm
Learners explain the process and significance of chemosynthesis. They develop their own graphic based on data of a biological community. They estimate the age of a given species as well.
Curated OER
Transformation With A Firefly Gene
High schoolers understand the process of bacterial transformation through experimentation. They describe the function of two important genes of the pBestLuc plasmid. They explain how to induce competence in E. coli cells.
Curated OER
Worksheet #6, Exponents, Interest, and Radioactive Decay of Isotopes
In this calculus worksheet, students sketch graphs of given exponential functions. They compute the principal needed to have a given ending balance when the interest is compounded at varying times. Students use a simple exponential model...
Curated OER
Water Quality and Nitrates & Phosphates
Pupils examine the effects of nitrates and phosphates on the dissolved oxygen levels in different water sources. In this series of 3 lessons, they consider the reasons for nitrate and phosphate level increases and their effects on...
Curated OER
"Keep it cool"
Students comprehend the importance of keeping cold foods cold. They identify the proper way to install and read a fridge thermometer. Students develop the ability to maintain a clean fridge at home.
Curated OER
Microbial Spoilers: The Impact of Microorganisms on the Shelf-life of Milk
Students are inroduced to a commonly used microbial culturing technique. They explore the role of microorganisms in determining the shelf-life of food products.
Curated OER
Water Quality Monitoring
Students comprehend the four parameters of water quality. They perform tests for salinity, dissolved oxygen, pH and clarity or turbidity. Students comprehend why scientists and environmental managers monitor water uality and aquatic...
Curated OER
The Portable Niche
Third graders, in groups, research animals, plants, and conditions found in ecosystems.
Curated OER
Changing the Water in the Aquarium
Students discover the importance and how to change the water in an aquarium. As a class, they review the types of impurities that are found in water and discuss how to keep the tank as clean as possible. They develop a water change...
Curated OER
Moore S Word Search Puzzle
In this literacy worksheet, students find the words that are in the word search puzzle that focus upon the vocabulary that is from the theme of the sheet.
Science Education Resource Center at Carleton College
Serc: Bacteria Growth Inquiry: Bodily Bacteria and Healthy Hygiene Habits
For this inquiry activity, groups of students will generate investigable questions to explore the link between hygiene/cleanliness and bacteria growth/population. They will record their processes and reflections in a journal and present...
Cells Alive
Cells Alive!: Bacteria Cam: Growth of Streptococcus Pneumoniae
Explore this bacterial growth sequence which begins four times daily (your local time) at midnight, 6 AM, noon, and 6 PM. A fresh image is loaded every minute.
TeachEngineering
Teach Engineering: Bacteria Are Everywhere!
Through this activity, students are introduced to the concept of engineering biological organisms and studying their growth to be able to identify periods of fast and slow growth. Students learn that bacteria are found everywhere,...
Bio Topics
Bio Topics: Experiments to Show the Growth of Bacteria
A activity to prove the basic techniques of the growth of bacteria.
Illustrative Mathematics
Illustrative Mathematics: F Le Bacteria Populations
This task provides a real-world context for interpreting and solving exponential equations. Students are asked to examine the equations representing the growth of three colonies of the bacterium that causes pneumonia, each colony being...
Texas Instruments
Texas Instruments: Logistic Growth
Students are introduced to logistic growth curves using a graphing calculator. Lab data includes the number of bacteria over a 20-hour period. The activity numerically approximates the derivative and uses regression to find a curve...
Cells Alive
Cells Alive: Bacterial Growth
This site provides a brief explanation of how bacteria cells grow and why they do not over run the earth. View actual bacteria growing by way of a time lapse movie.
Middle School Science
Middle School Science: Where Can We Find Bacteria?
In this experimental site, you will find out where bacteria hang out and determine what kind of environmental conditions influence bacterial growth. Directions are clear and complete.
Other popular searches
- Bacteria Growth Requirements
- Bacteria Growth on Bread
- Bread Bacteria Growth
- Bacteria Growth Safety
- Exponential Bacteria Growth
- Bacteria Growth Medium Agar
- Germs Bacteria Growth
- Bacteria Growth Requirenents
- Bacteria Growth on Pizza
- Bacteria Growth Rate